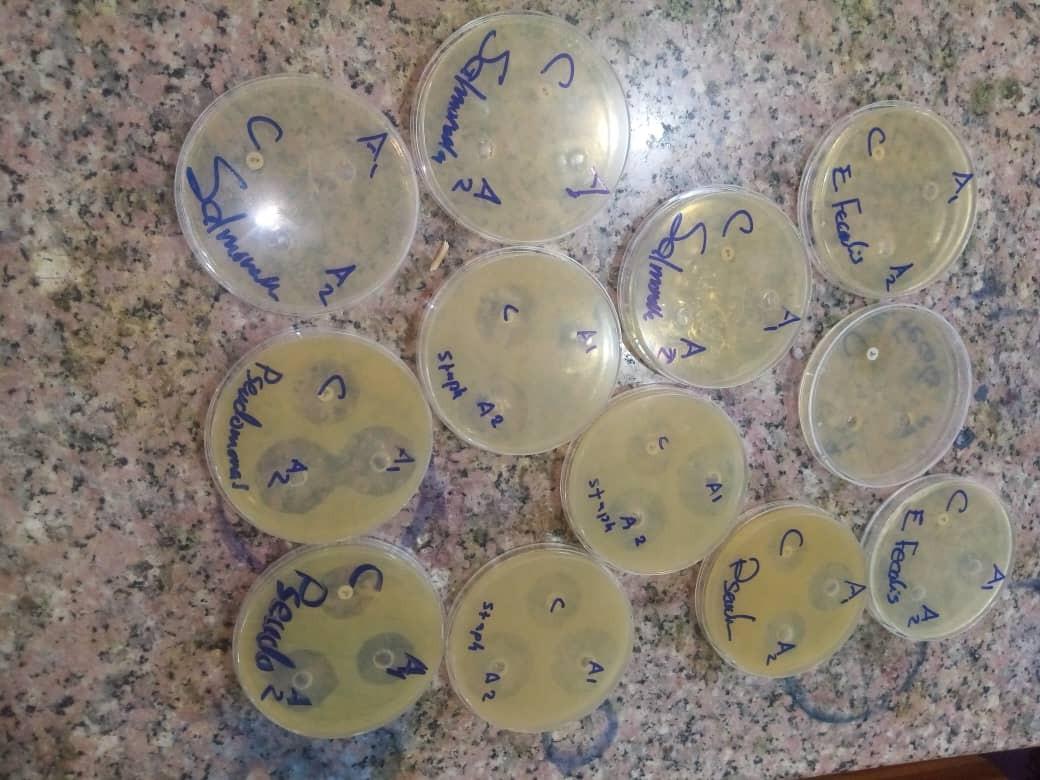
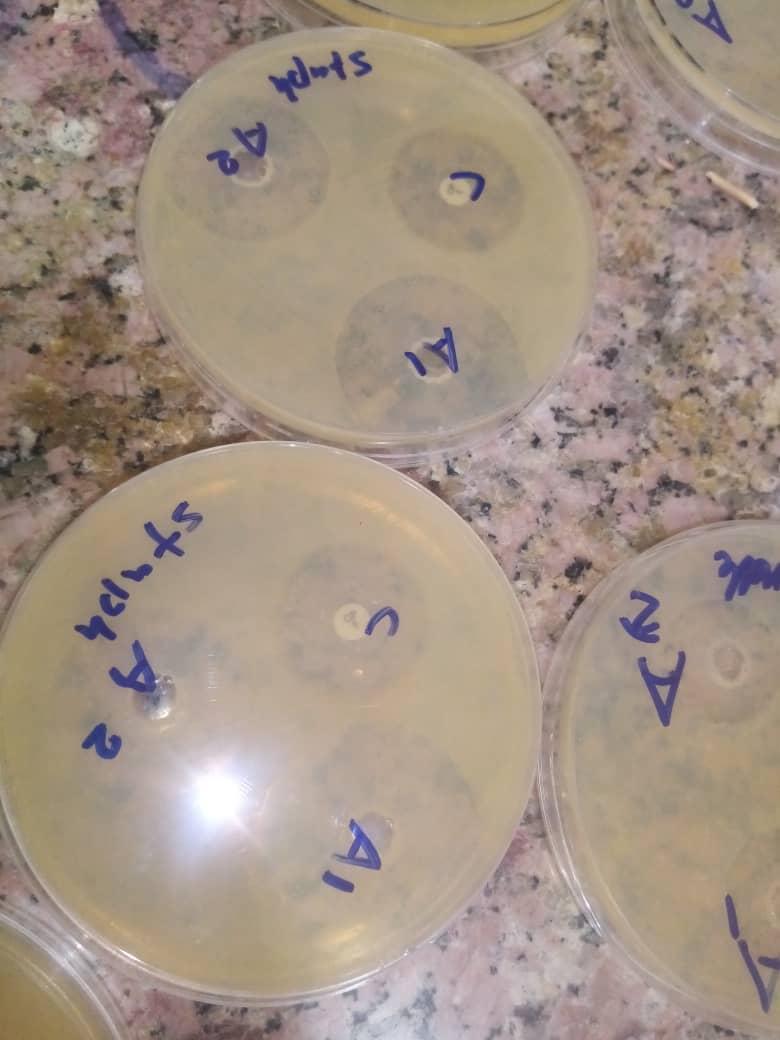

Detection of Antibacterial Activity of Aqueous Extract of Allium Sativa Against some Human pathogenic Bacteria
- Department of Graduate College and Scientific Studies, Gharb El-Niel College, Sudan
- Department of Medical Laboratory Sciences, Dar ALaloum College, Sudan
- Ahfad University for Women, Sudan
Abstract
Background: Garlic (Allium sativum) has long been used for the treatment of bacterial infections. This study aimed to evaluate the in vitro antibacterial activity of an aqueous garlic extract against five clinically important bacterial strains: Staphylococcus aureus, Escherichia coli, Salmonella Paratyphi B, Pseudomonas aeruginosa, and Enterococcus faecalis.
Methods: A cross-sectional, laboratory-based study was conducted at Gharb Alneel College of Medical Laboratory Science. Two concentrations of the aqueous extract (1 g/mL and 0.5 g/mL) were tested against the selected organisms using the agar-well diffusion assay.
Results: At 1 g/mL, the extract produced zones of inhibition of 14 mm (E. faecalis), 40 mm (E. coli), 45 mm (S. aureus), 22 mm (S. Paratyphi B), and 40 mm (P. aeruginosa). At 0.5 g/mL, the corresponding zones were 10 mm, 30 mm, 30 mm, 30 mm, and 35 mm, respectively. Ciprofloxacin (positive control) yielded zones of 10 mm, 20 mm, 40 mm, 22 mm, and 30 mm against the same isolates.
Conclusion: The aqueous Allium sativum extract exhibited broad-spectrum antibacterial activity, notably against P. aeruginosa, E. coli, S. aureus, and S. Paratyphi B, while showing only limited efficacy against E. faecalis.
Introduction
The World Health Organization (WHO) recommends, after conducting extensive toxicological and experimental studies, the use of herbal medicines as alternative therapeutic agents 1. Antibacterial resistance has become a major global health problem 2. In 1979, both Staphylococcus aureus and coagulase-negative staphylococci were reported to be resistant to vancomycin 3. Garlic (Allium sativa) has long been used as an anti-infective agent 4,5, and belongs to the family Alliaceae 6.
In the present study, an aqueous garlic extract was evaluated using the well-diffusion method to determine its antibacterial activity against Escherichia coli, Staphylococcus aureus, Salmonella Paratyphi B, Pseudomonas aeruginosa, and Enterococcus faecalis. Allium sativa is widely employed in traditional medicine in many developing countries 7,8. This investigation highlights the escalating problem of antibiotic resistance and the potential of herbal remedies, such as garlic extract, as alternative therapeutic options. Although numerous studies in Sudan have examined the antimicrobial potential of various plants, few have specifically evaluated the antibacterial properties of garlic. Therefore, this study aimed to determine the in vitro antibacterial activity of an aqueous garlic (Allium sativa) extract against selected human pathogenic bacteria.
Methods
The study was designed as a cross sectional laboratory based study.It was conducted in Gharb Alneel College of medical Laboratory science .
Study duration
From February to August 2023.
Sample size
The study was conducted on stander strain of obtained from:the national health laboratory in Khartoum. Sudan
Materials
Pure garlic: Was obtained from the local market and was identifiedfromUniversity of KhartoumFaculty of Veterinary, Rasearch center. Culture media: Muller Hinton agar media; for sensitivity tests. Reagents: Concentrated sulphuric acid, Barium chloride. Other requirements: Sterile normal saline from pharmacy (0.9%), Ciprofloxacin antibiotics: (controls for sensitivity tests).
Preparation of fresh garlic
Garlic bulbs were peeled, and 50 g of clove pulp was cut into small pieces, blended, and homogenized with 50 mL of sterilized distilled water for 1 min every 10 min for a total of 1 h using an Isolab laboratory blender (Germany). The homogenate was then filtered through eight layers of muslin cloth into a calibrated 100 mL volumetric flask; the solid residue was washed several times with distilled water, and the combined filtrates were adjusted to volume to obtain a 50 % (w/v) garlic aqueous extract (GAE). The extract was refrigerated at 4 °C in an airtight glass bottle until use. In addition, a 100 % (w/v) GAE was prepared by homogenizing 100 g of garlic pulp following the method of Jolly et al. (2022) with slight modifications 9,10.
Sensitivity testing
Preparation of Mueller Hinton agar and McFarland:
Barium sulfate was used to adjust the turbidity of the inocula. A 1 % (v/v) sulfuric acid solution was prepared by adding 1 mL of concentrated sulfuric acid to 99 mL of distilled water. A 1.17 % (w/v) barium chloride solution was obtained by dissolving 2.35 g of barium chloride dihydrate in 200 mL of distilled water. To prepare the turbidity standard, 0.5 mL of the barium chloride solution was mixed with 99.5 mL of the sulfuric acid solution.
Antibacterial sensitivity testing using well diffusion method:
Colonies of bacteria were suspended in sterile normal saline (0.9 %) and adjusted to approximately 10 colony-forming units (CFU) according to the McFarland standard. Mueller–Hinton agar was cooled to 45 °C; 25 mL of medium was dispensed into each 90-mm Petri dish, after which 200 µL of the bacterial suspension was gently mixed into the molten agar. Once the agar had completely solidified, three circular wells (10 mm in diameter) were cut into the medium with a sterile test tube, and the agar plugs were removed. Using an adjustable pipette, two wells were filled with 100 µL of Allium sativum extract (AGE) at 1 g/mL and 500 mg/mL, respectively, whereas the third well received the control antibiotic. The plates were kept at room temperature for 40 min and then incubated upright overnight at 37 °C 10.
Ethical clearance
Ethical approval was obtained from the Ministry of Health Ethical Research Committee (No.MH-RES/07-023-09, date 1/2/2023) in accordance with the Declaration of Helsinki Principles. The agreement was taken from Hospital administration before the sample and data collection.
Statistical analysis
Mean values of all parameters were compared using the student’s t-test to detect the differences (p≤0.05).
Results & Discussion
Aqueous garlic extract was evaluated against standard strains of Escherichia coli, Staphylococcus aureus, Salmonella Typhi, Pseudomonas aeruginosa, and Enterococcus faecalis using the well-diffusion assay. Two concentrations of the extract were tested (A1, 1 g/mL, and A2, 0.5 g/mL), with ciprofloxacin serving as the positive control. The diameters of the zones of inhibition obtained with the different concentrations of garlic extract were as follows:
Zone of inhibition of A1 (concentration of garlic extract 1g/ml), A2 (concentration of garlic extract 500mg/ml) and C (control:( ciprofloxacin) against E.faecalis.
Zone of inhibition of A1 (concentration of garlic extract 1g/ml), A2 (concentration of garlic extract 500mg/ml) and C (control: (ciprofloxacin) against Staph.aureus.

Zone of inhibition of A1 (concentration of garlic extract 1g/ml), A2 (concentration of garlic extract 500mg/ml) and C (control: (ciprofloxacin) against salmomalla typhi.

Zone of inhibition of A1 (concentration 1g/ml), A2 (concentration 500mg/ml) and C (control: (ciprofloxacin) against Ps.aeruginosa.
Zone of inhibition (mm)
| Bacteria | Control | A1 | A2 |
|---|---|---|---|
| 40 | 45 | 30 | |
| 20 | 40 | 30 | |
| 22 | 22 | 30 | |
| 30 | 40 | 35 | |
| 10 | 14 | 10 |
This table show zone of inhibition of control : (ciprofloxacin),aqueous garlic extract (1g/ml) and aqueous garlic extract(500mg/ml) against E. coli, staphylococci aureus, salmonella typhi, pseudomonas and E.faecalis.

Zone of inhibition (mm). This figure show zone of inhibition of control :(ciprofloxacin),aqueous garlic extract (1g/ml) and aqueous garlic extract(500mg/ml) against E. coli, staphylococci aureus, salmonella typhi, pseudomonas and E.faecalis.
Compare means for zone of inhibition between concentration 1 and control
| Mean | N | Std. Deviation | P.Value | ||
|---|---|---|---|---|---|
| Pair 1 | A1 | 2.40 | 5 | 1.140 | .208 |
| control | 3.00 | 5 | 1.581 | ||
Compare means for zone of inhibition between concentration 2 and control: Group Statistics
| Mean | N | Std. Deviation | P.Value | ||
|---|---|---|---|---|---|
| Pair 1 | A2 | 1.60 | 5 | .894 | .025 |
| control | 3.00 | 5 | 1.581 | ||
In the present study, we evaluated the antibacterial activity of an aqueous garlic extract against selected Gram-positive (Staphylococcus aureus and Enterococcus faecalis) and Gram-negative ( Escherichia coli, Salmonella typhi para B, and Pseudomonas aeruginosa) bacteria, findings that are consistent with previous reports 11,12.
The results of the present study demonstrated that the zone of inhibition at 1 g/mL garlic concentration against Enterococcus faecalis, Escherichia coli, Staphylococcus aureus, Salmonella Paratyphi B, and Pseudomonas aeruginosa was 14 mm, 40 mm, 45 mm, 22 mm, and 40 mm, respectively. At a concentration of 500 mg/mL, the respective inhibition zones were 10 mm, 30 mm, 30 mm, 30 mm, and 35 mm. The positive control, ciprofloxacin, produced inhibition zones of 10 mm, 20 mm, 40 mm, 22 mm, and 30 mm against the same bacterial species.
The findings of this study demonstrate that aqueous garlic extract is effective against bacteria, corroborating previous reports 13,14,15,16,17. Statistical analysis revealed a significant difference in antimicrobial activity between the aqueous garlic extract and the control agent, ciprofloxacin. and were more susceptible to the fresh garlic extract than to ciprofloxacin, possibly because they have developed resistance to this fluoroquinolone. was the least susceptible of the tested organisms, exhibiting a mean growth-inhibition zone of 5 mm in response to the garlic extract 18.
The study recommends additional research on the safety profile of garlic extract and its suitability for various applications, as this would provide a more comprehensive understanding of its potential benefits and limitations. Further studies should elucidate the mechanisms of action of garlic extract as an antimicrobial agent and discuss the potential implications for the development of new antibacterial treatments. A more in-depth analysis of the results and their broader implications is warranted. Recommendations for future research include investigating the optimal concentrations of garlic extract for different bacterial strains and exploring potential synergistic effects with other antimicrobial agents. Additionally, the study should address its limitations and identify areas requiring further investigation. Although the current work provides valuable insights into the antibacterial activity of garlic extract, there remains room for improvement, particularly in providing more detailed descriptions of the methodology, results, and discussion.
Study limitation
The manuscript does not adequately address the potential side effects, contraindications, or other safety considerations associated with the use of garlic extract as an antimicrobial agent, particularly in its proposed role as a natural preservative within the food industry. Significant limitations persist, including methodological challenges intrinsic to phytotherapeutic research and substantial gaps in the current evidence base—most available studies assess only a narrow spectrum of pathogens and omit several clinically relevant strains that are prevalent in Sudan. Moreover, the presentation of the results is cursory: patterns or trends are not systematically described, comparisons with previous investigations are limited, and the implications of the findings for the stated objectives are insufficiently discussed.
Conclusion
The study revealed that whole Allium sativum extract inhibited the growth of a broad range of bacteria, including , and , but it showed no efficacy against . The authors recommended that aqueous garlic extract (AGE) could be used as a natural antimicrobial preservative in the food industry because of its potent antimicrobial properties.
Consent for publication
Availability of data and materials
Competing interests
Funding
This research did not receive any specific grant from funding agencies in the public, commercial, or not- for- profit sectors.
Author’s contribution
EAM and AA1 conceived the design and carried out the experiments. EAM and MAH obtained, analyzed and interpreted the data. MAH and AA1 wrote and revised the manuscript. AAI and MAH provides financial support for all experiments. All authors have critically reviewed and approved the final draft and are responsible for the content and similarity index of the manuscript.
Acknowledgements
Thanks for all participants involved in this research.